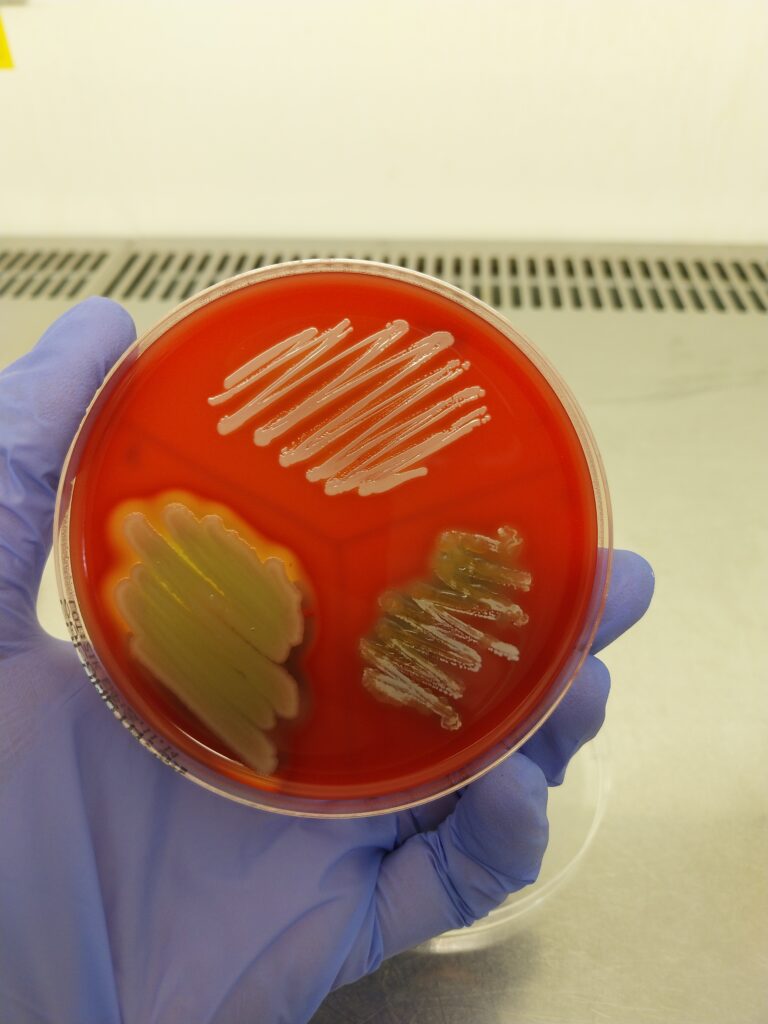

O curso “Apoio ao ensino–aprendizagem em ciências biológicas: formação prática sobre as interações hospedeiro-microrganismos” concluiu a sua última sessão no dia 25 de outubro de 2025, assinalando o encerramento de uma etapa formativa que proporcionou aos participantes uma atualização científica no domínio da microbiologia e das interações hospedeiro-microrganismos. A iniciativa visou contribuir para o fortalecimento da Agência Curricular dos formandos, potenciando a inovação na prática pedagógica em estreita articulação com o literatura de referência e currículo.
Desenvolvido em parceria entre a Universidade de Aveiro, a Faculdade de Ciências da Universidade do Porto (FCUP) e o Centro Ciência Viva de Vila do Conde, o curso beneficiou de uma articulação interinstitucional que possibilitou um desenho formativo mais rico, colaborativo e responsivo às necessidades dos professores em exercício.
Ao longo da formação, foram exploradas diferentes metodologias, experimentais e didáticas, que visam apoiar a investigação em ensino da Biologia e o aprimoramento das práticas pedagógicas dos formandos, promovendo uma aprendizagem ativa e reflexiva, em estreita ligação com o contexto escolar.
As evidências recolhidos no âmbito desta formação serão analisados no prosseguimento do projeto, contribuindo para compreender o impacto das estratégias exploradas no desenvolvimento profissional docente e na desenvolvimento curricular.
Esta formação integrou-se no programa EduBiota, dedicado à promoção da educação científica e à disseminação do conhecimento sobre biodiversidade microbiana. Mais informações sobre o EduBiota podem ser consultadas em https://blogs.ua.pt/cidtff/?p=74552.